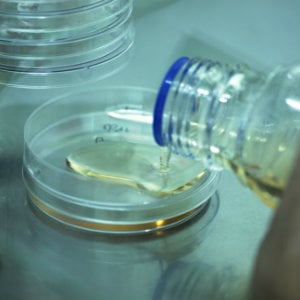

Jul 3, 2014 7:30:00 AM
- Company
- Leadership
- Investors
- Our Commitment
- News
- Careers
- STAY UP TO DATE SUBSCRIBE
- QUESTIONS OR SUPPORT CONTACT US
- QUALITY TESTING Environmental Monitoring
- Bioburden Testing
- Water Testing
- Sterility Testing
- SEE IT IN ACTION Request A Demo
- HAVE A QUESTION? Connect with us today
.jpg)